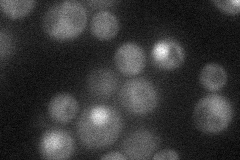
YDR451C
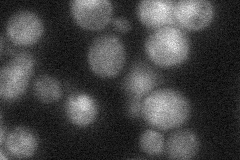
YDR451C

View description
One of two homeobox transcriptional repressors (see also Yox1p), that bind to Mcm1p and to early cell cycle box (ECB) elements of cell cycle regulated genes, thereby restricting ECB-mediated transcription to the M/G1 interval
Localization:
Intensity:
Fold change:
Significance:
-
C’ GFP library in SD

nucleus18.27 -
N' NOP1pr-GFP in SD
nucleus33.3632 -
N' TEF2pr-mCherry in SD

below threshold4.92132 -
N' NATIVEpr-GFP in SD
below threshold31.7907 -
N' TEF2pr-VC and Cyto-VN in SD

#N/A0 -
C’ GFP library in SD+DTT

nucleusN/AN/AYes -
C’ GFP library in SD+H2O2

nucleus20.221.1No -
C’ GFP library in Starvation Media

nucleus23.811.3No -
C’ GFP library on the background of Pup2-DaMP

N/A -
C’ GFP library on the background of CCT mutant

N/A0N/AYes
